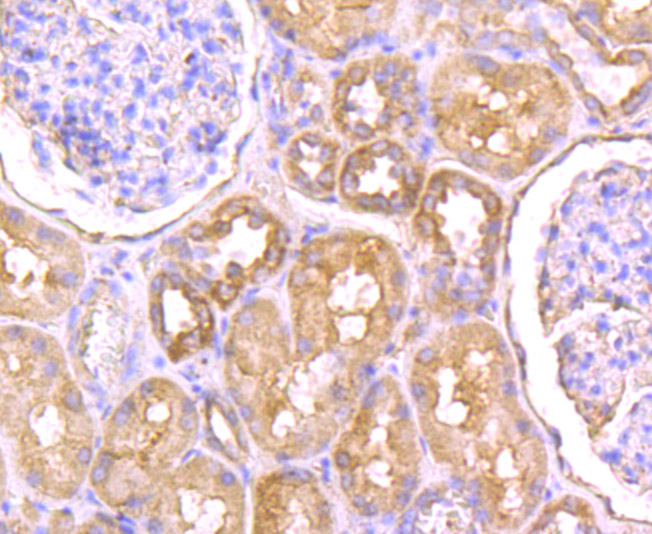

-
Product Name
Anti-SCN9A antibody
- Documents
-
Description
Mouse monoclonal antibody to SCN9A
-
Tested applications
IHC-P, ICC, FC, WB
-
Species reactivity
Human
-
Alternative names
PN1 antibody; ETHA antibody; NENA antibody; SFNP antibody; FEB3B antibody; NE-NA antibody; GEFSP7 antibody; HSAN2D antibody; Nav1.7 antibody
-
Isotype
Mouse IgG2b
-
Preparation
This antigen of this antibody was synthetic peptide within human nav1.7 aa 1570-1620 (extracellular).
-
Clonality
Monoclonal
-
Formulation
Liquid, 1*PBS (pH7.4), 0.2% BSA, 50% Glycerol. Preservative: 0.05% Sodium Azide.
-
Storage instructions
Store at +4℃ after thawing. Aliquot store at -20℃ or -80℃. Avoid repeated freeze / thaw cycles.
-
Applications
ICC: 1:50-1:200
IHC-P: 1:50-1:200
FC: 1:50-1:200
WB: 1:500
-
Validations

Fig1: ICC staining NaV1.7 (green) in A549 cells. The nuclear counter stain is DAPI (blue). Cells were fixed in paraformaldehyde, permeabilised with 0.25% Triton X100/PBS.

Fig2: ICC staining NaV1.7 (green) in Hela cells. The nuclear counter stain is DAPI (blue). Cells were fixed in paraformaldehyde, permeabilised with 0.25% Triton X100/PBS.

Fig3: Immunohistochemical analysis of paraffin-embedded human colon cancer tissue using anti-NaV1.7 antibody. Counter stained with hematoxylin.
Fig4: Immunohistochemical analysis of paraffin-embedded human kidney tissue using anti-NaV1.7 antibody. Counter stained with hematoxylin.

Fig5: Flow cytometric analysis of A549 cells with NaV1.7 antibody at 1/50 dilution (blue) compared with an unlabelled control (cells without incubation with primary antibody; red). Goat anti mouse IgG (FITC) was used as the secondary antibody.
- Background
-
References
- Henningsen K et al. Candidate hippocampal biomarkers of susceptibility and resilience to stress in a rat model of depression. Mol Cell Proteomics 11:M111.016428 (2012).
- Weiss J et al. Loss-of-function mutations in sodium channel Nav1.7 cause anosmia. Nature 472:186-90 (2011).
Related Products / Services
Please note: All products are "FOR RESEARCH USE ONLY AND ARE NOT INTENDED FOR DIAGNOSTIC OR THERAPEUTIC USE"
